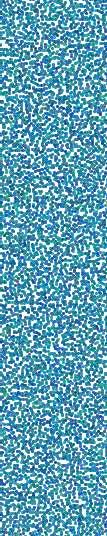
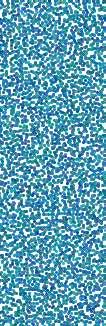

PARCELAMENTO URBANO PARCELAMENTO URBANO
ESTUDO E PROPOSTA DE REVITALIZAÇÃO URBANÍSTICA NA REGIÃO PRÓXIMA A RODOVIÁRIA DE GOIÂNIA

















































discentes: Fernanda Sagan, Hanna Lima, Maressa Gonçalves e LucasVenâncio
orientadoras:Erika CristineKneib eCarolina Rodrigues Boaventura



















































ContextoeObjetivo Diagnóstico Metodologia Centralidades Localização Topografia Vias MassasVerdes Gabaritos Usos Partido ProblemasePotenciais PrincípioGerador DiagramadePartido Comparaçãocomo existente Projeto MapadaProposta DiagramadeVias Cortes PerfildasVias SetorizaçãoeEquipamentos TaxaseGabaritos Perspectivas SUMÁRIO 04 06 07 08 10 12 14 16 18 20 22 23 24 26 28 30 32 34 36 36 38 40 42
CONTEXTO E OBJETIVO
O centro de Goiânia é um espaço plural e que abriga áreasdegrandevalorurbanístico.Suacapacidade de aproximar construções históricas a poloscomerciaisébastanteenriquecedora,oquefazcomque a demanda habitacional seja alta.
Porémfazpartedoaprendizado de Arquitetura e Urbanismo pensar os espaços de maneira útil e confortável. Foi a partir disso que se pensou esse projeto. Buscamos por meio dele propor uma revitalização deumaáreapróximaaRodoviáriadeGoiâniaedaRua44.



DIAGNÓSTICO
METODOLOGIA
Aequiperealizouumavisita de campo a fim de levantar dados e fotografias a respeito dos aspectos urbanos da área. A partir desse momento foram produzidos mapas e diagramas para visualizar o diagnóstico e pensar o partido da intervenção.
Com o auxílio do diagnósticoedoconhecimentodeurbanismo,desenvolveu-seopartido até o projeto de proposta a ser apresentado.
MAPA DE CENTRALIDADES

Aáreademarcadaselocaliza a 2,5km do centro da cidade.Ospolospróximosàsão predominantemente comerciais(regiãoda44,SetorCampinas e os shoppings Cerrado e Estação Goiânia. Os centros educacionais se localizam à 2,77kmeosprincipaispolosempresariais da cidade estão a umadistânciade4km.





















































LEGENDA
CentrodeGoiânia
PoloEmpresarial
PoloEstudantil
PoloComercial
ÁreadeEstudo

























































MAPA DE LOCALIZAÇÃO























Aáreaestudadaédelimitadaemparteporduasavenidas importantes em Goiânia: Av. Goiás e a Av. Leste - Oeste. Além dessas, o terreno possui fácil acesso à demais avenidas degrandesfluxoscomoaBotafogo.










Se encontra centralizada na cidade próxima aos bairros históricos.














LEGENDA
viaexpressa2ªcategoria


Av.MarginalBotafogo
viaarterial1ªcategoria


Av.Goiás
viaarterial2ªcategoria
Av.Independência
Av.Araguaia
Av.MarechalRondon
Av.Paranaíba
Av.Oeste (trecho entre Av. Marechal


Rondon e Av. Goiás)

Av.Leste-Oeste
viacoletora
Av.Oeste
Av.Contorno
























































MAPA DE TOPOGRAFIA












Atopografiadaáreaébastante acentuada por se tratardeumagrandeárea,otraçado de algumas ruas parecem seguir o desenho topográfico. Além disso, a área possui uma paraumvale,ondepassaocórregoCapimPuba.






























LEGENDA













Partemaisalta
Partemaisbaixa
























































MAPA DE VIAS























Aáreaemquestãoédelimitadapordiversasviasimportantes para a região e muitas de fluxo intenso, porém a maior parte das vias presentes dentro daáreasãodecaráterlocal,já que a região é predominantementeresidencial.















LEGENDA
Viaarterial





Viaarterial1ªcategoria
Viaarterial2ªcategoria
Viacoletora
Vialocal




































































MAPA DE MASSAS VERDES


Por ser uma área nas margens de um rio, esse terreno possuiumavegetaçãoquepermeia homogeneamente toda sua área. Nota-se claramente queamargemdorionãofoirespeitada.
































LEGENDA ÁreasVerdes
ÁreasPermeáveiscomPotencialVerde

























LotesBaldiosPermeáveis
ResquíciodeMataCiliar
Árvores
Água
























































MAPA DE VIAS























A maior parte das edificações contidas na área de estudo é composta por um pavimento, as de 2 ou mais pavimentos são pontuais, e as de 4 oumaispavimentosseconcentram principalmente na quadra daLeroyMerlinenaquadrade condomíniosresidenciais.

















A taxa de ocupação e aproveitamentosãobemvariadas de acordo com cada quadra e seus respectivos usos, comomostraatabela.
LEGENDA
1Pavimento















2ouMaisPavimentos
APartirde4Pavimentos

























































MAPA DE USOS DO SOLO
Aáreaéemsuamaioriaresidencial. No entanto, possui uma quantidade considerável de comércios em maioria concentrados em uma grande faixa. Isso ocorre por dois motivosprincipais,oprimeirodelesé a presença de avenidas importantesquecruzamaáreanessa região e o outro é a proximidade com a região da 44, que se tratadeumaáreacombastantefluxoequeatraimuitaspessoas.












LEGENDA
Institucional


Educacional
Residencial




























Comercial
Serviços
Saúde












Lazer
PatrimônioTombado
























































PARTIDO
PROBLEMAS
baixapermeabilidade traçadobastanteirregular fluxomaldistribuído faltadeviacoletoras comércio concentrado em umúnicoponto muitas residências próximas aocórrego
desvalorizaçãodopedestre
POTENCIAIS
baixa densidade demográfica (possibilidade de realocaçãodosmoradores)
regiãopróximaagrandepolo comercial
região delimitada por importantesvias
PRINCÍPIO GERADOR
Oprincípiogeradordopartidoforamdoisgrandesparques paralelosqueseiniciamnaAvenidaGoiáseseguematéaAvenidaLesteOeste.
O primeiro parque permeia oRibeirãofazendodivisacomo cemitério e tem a função de preservar o córrego, mas também servirá como espaço de lazer para a população, abrigando pequenos quiosques.
Jáosegundoparqueservirá como espaço de transição e que além de separar a área mais pedestrializada das áreas de maior movimento de veículos, também servirá como barreira acústica, minimizando os ruídos vindos das vias arteriais e daregiãoda44.
croquis parque linear, fonte: Espacio Coletivo + OPUS, 2016
DIAGRAMA DE PARTIDO
Partindo do príncipio dos parqueslineares,organizamosa áreademodoaprivilegiaropedestre.
Asavenidasforamdispostas seguindo a topografia e se ligandoaviasarteriaisjáexistentes.
Calçadões interligam os parques, reduzem o tamanho dasquadrasedãoacessoaum centrocomercial.
LEGENDA
viasarteriais
viascoletoras
viaslocais
viasdepedestres parques
RibeirãoAnicuns
COMPARAÇÃO COM O EXISTENTE
Ao aplicar a mesma composição gráfica no layout exis tenteépossívelnotarasmudan


























































































































































































































viasdepedestres
RibeirãoAnicuns
























































PROJETO
IDEAIS
O projeto se inicia então a partir dosparques lineares e da vontade de privilegiar o pedestre.
Paraatrair umfluxodepessoas para aquela área e não limita-la ao uso residencial, planeja-se uma faixa comercial entre os dois parques. Seu acesso se dá por meio de um calçadão, que também a liga àsáreasverdes.
As vias foram dispostas de modoaperimetrarosparquese seguir a topografia natural do terreno. Com as vias locais tentamos não criar quadra muitos extensas que inibissem a caminhada. Todas as ruas possuem umperfilcapazdeincentivardiferentesmeiosdetransporte.
MAPA DA PROPOSTA


















































































































































parcelamentoexistente:537lotes





































































































































novoparcelamento:490lotes





































































































































































































































































































































































































DIAGRAMA VIAS

























































LEGENDA
viasarteriais viascoletoras viaslocais
viasdepedestres parques
RibeirãoAnicuns
Av.MarechalRondon














Av.Goiás Av.Leste-Oeste
AntigaEstaçãoFerroviária
CORTE DA RELAÇÃO ENTRE OS PARQUES





























escala1:950























































AA

















escala1:650 BB CC
CORTES
AA BB CC
SETORIZAÇÃO E EQUIPAMENTOS
Oslotescomedifícios serão mais adensados, por isso serão dispostos na parte sudoeste, próximoamaisviasquefacilita rãooescoamento.
Serácriadaumaregiãodes tinada a comércios locais e equipamentos institucionais (2) na centralidade entre os parques com vias pedestralizadas, a fim de estimular o menor uso decarros.





As demais quadras serão destinadas a lotes residenciais (3) com pouca verticalização, uma vez que a área está em uma região centralizada, próxi ma a vias importantes e de um polo comercial. Além de que, tende a se valorizar mais ainda comacriaçãodosparques. As quadras mais próximas do movimento serão destinadas a comérciosdeloja(4).
A Estação Ferroviária foi preservadacomolazercultural.
LEGENDA
Árearesidencialverticalizada
Comercioeinstitucional
Residencial

Usomisto
Parques
Bibliotecapúblicaeescola
Igrejas


















































































































































































































































































































































































































































































































PostodeSaúde
Bolsõesdeestacionamento
1 2 3 4
























TAXAS E GABARITOS
Índicesantes:
áreaconstruída(projeção)=4.667,69m² taxadeocupação=57% permeabilidade=14% coeficientedeaproveitamento=72%
Índicesdepois:
áreaconstruída(projeção)=2.078,92m² taxadeocupação=36% permeabilidade=34% coeficientedeaproveitamento=110%



LEGENDA
Até2pavimentos
Até3pavimentos
Até4pavimentos
Até7pavimentos

























































































































rua pedestralizada, fonte: autores, 2023











































































































relação biblioteca e parque, fonte: autores, 2023











































































































rua do parque com ciclovia, fonte: autores, 2023
REFERÊNCIAS
Valencia,Nicolás. Segundafase do Corredor Verde de Cali na Colômbia [Así será la segunda fasedelCorredorVerdedeCali enColombia]02Fev2016.ArchDaily Brasil. (Trad. Santiago Pedrotti,Gabriel)Acessado13Fev 2023. <https://www.archdaily.com.br/br/781254/assim-sera-a-segunda-fase-do-corredor-verde-de-cali-em-colombia> ISSN 0719-8906